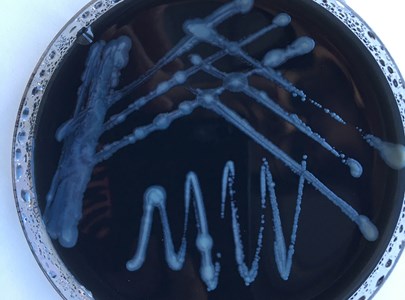

Wo sind die Spielgruppen?
Ossingen - Bildung, Betreuung oder Freizeit? Die unklare Zuteilung macht Spielgruppen zu schaffen und wirkt sich auf die finanzielle Situation aus. Manuela Schweizer wagt einen Vorstoss. Ob der Gemeinderat darauf eingeht, zeigt sich Mitte Mai.
05. Mai 2020